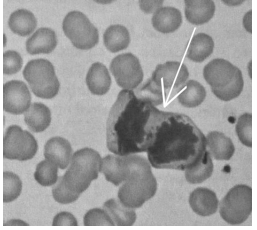
associated-text-c54f0bed2ef558ef0f2dcdccd76e4d1d6f9e8e40eccdd6da9a0d3f94c004ccd2-108-0.jpg

Papiloscopista Policial Federal - 2018
A respeito de arquivologia, julgue o item seguinte.
A estabilidade química do material e sua resistência aos agentes de degradação são fundamentais para o acondicionamento dos documentos de arquivo.
A respeito de arquivologia, julgue o item seguinte.
A preservação dos documentos de arquivo inicia-se quando o documento chega ao arquivo permanente.
Em um bairro nobre de determinada cidade no Brasil, houve um assassinato na madrugada fria do mês agosto. A vítima, um homem de quarenta e dois anos de idade, foi encontrada morta com golpes de faca na região torácica. Sua residência tinha sido saqueada e exibia sinais de violação, como, por exemplo, uma janela quebrada que estava manchada de sangue. Como havia sinais de que a vítima pudesse ter resistido ao ataque e revidado até ser imobilizada e morta, amostras biológicas do corpo da vítima foram coletadas pelos investigadores e encaminhadas para análise, a fim de se obterem evidências que levassem à identificação do assassino. Uma das amostras de sangue recolhidas no local do crime promovia aglutinação de hemácias somente na presença de soro anti-B e de soro anti-Rh; outra amostra não apresentava aglutinação na presença de soros anti-A, anti-B e anti-Rh. Durante a investigação, descobriu-se, ainda, que a vítima sofria de hemofilia e que uma amostra de sangue de tipo sanguíneo diferente do da vítima apresentava mutação no alelo do fator VIII. Após vários meses de investigação, os investigadores chegaram a um suspeito, que era portador do tipo sanguíneo A negativo.
Considerando a situação hipotética apresentada e os múltiplos aspectos a ela relacionados, julgue o item a seguir.
Na ausência de outras evidências que o ligassem ao fato, o suspeito poderia ser liberado, pois seu tipo sanguíneo não é o mesmo dos tipos sanguíneos encontrados nas duas amostras mencionadas, que correspondem, na ordem em que aparecem no texto, aos tipos sanguíneos B positivo e O negativo.
Em um bairro nobre de determinada cidade no Brasil, houve um assassinato na madrugada fria do mês agosto. A vítima, um homem de quarenta e dois anos de idade, foi encontrada morta com golpes de faca na região torácica. Sua residência tinha sido saqueada e exibia sinais de violação, como, por exemplo, uma janela quebrada que estava manchada de sangue. Como havia sinais de que a vítima pudesse ter resistido ao ataque e revidado até ser imobilizada e morta, amostras biológicas do corpo da vítima foram coletadas pelos investigadores e encaminhadas para análise, a fim de se obterem evidências que levassem à identificação do assassino. Uma das amostras de sangue recolhidas no local do crime promovia aglutinação de hemácias somente na presença de soro anti-B e de soro anti-Rh; outra amostra não apresentava aglutinação na presença de soros anti-A, anti-B e anti-Rh. Durante a investigação, descobriu-se, ainda, que a vítima sofria de hemofilia e que uma amostra de sangue de tipo sanguíneo diferente do da vítima apresentava mutação no alelo do fator VIII. Após vários meses de investigação, os investigadores chegaram a um suspeito, que era portador do tipo sanguíneo A negativo.
Considerando a situação hipotética apresentada e os múltiplos aspectos a ela relacionados, julgue o item a seguir.
Como as hemácias possuem núcleos, amostras de DNA poderiam ser obtidas a partir do isolamento dos núcleos das hemácias presentes nas manchas de sangue nos destroços de vidro.
Em um bairro nobre de determinada cidade no Brasil, houve um assassinato na madrugada fria do mês agosto. A vítima, um homem de quarenta e dois anos de idade, foi encontrada morta com golpes de faca na região torácica. Sua residência tinha sido saqueada e exibia sinais de violação, como, por exemplo, uma janela quebrada que estava manchada de sangue. Como havia sinais de que a vítima pudesse ter resistido ao ataque e revidado até ser imobilizada e morta, amostras biológicas do corpo da vítima foram coletadas pelos investigadores e encaminhadas para análise, a fim de se obterem evidências que levassem à identificação do assassino. Uma das amostras de sangue recolhidas no local do crime promovia aglutinação de hemácias somente na presença de soro anti-B e de soro anti-Rh; outra amostra não apresentava aglutinação na presença de soros anti-A, anti-B e anti-Rh. Durante a investigação, descobriu-se, ainda, que a vítima sofria de hemofilia e que uma amostra de sangue de tipo sanguíneo diferente do da vítima apresentava mutação no alelo do fator VIII. Após vários meses de investigação, os investigadores chegaram a um suspeito, que era portador do tipo sanguíneo A negativo.
Considerando a situação hipotética apresentada e os múltiplos aspectos a ela relacionados, julgue o item a seguir.
Dada a possibilidade de se identificar uma pessoa com base no padrão de polimorfismos presentes no genoma de cada indivíduo, análises do perfil de DNA presente nos núcleos de células obtidas em amostras de manchas de sangue recuperadas no local do crime podem ser usadas para levar criminosos à condenação.
Em um bairro nobre de determinada cidade no Brasil, houve um assassinato na madrugada fria do mês agosto. A vítima, um homem de quarenta e dois anos de idade, foi encontrada morta com golpes de faca na região torácica. Sua residência tinha sido saqueada e exibia sinais de violação, como, por exemplo, uma janela quebrada que estava manchada de sangue. Como havia sinais de que a vítima pudesse ter resistido ao ataque e revidado até ser imobilizada e morta, amostras biológicas do corpo da vítima foram coletadas pelos investigadores e encaminhadas para análise, a fim de se obterem evidências que levassem à identificação do assassino. Uma das amostras de sangue recolhidas no local do crime promovia aglutinação de hemácias somente na presença de soro anti-B e de soro anti-Rh; outra amostra não apresentava aglutinação na presença de soros anti-A, anti-B e anti-Rh. Durante a investigação, descobriu-se, ainda, que a vítima sofria de hemofilia e que uma amostra de sangue de tipo sanguíneo diferente do da vítima apresentava mutação no alelo do fator VIII. Após vários meses de investigação, os investigadores chegaram a um suspeito, que era portador do tipo sanguíneo A negativo.
Considerando a situação hipotética apresentada e os múltiplos aspectos a ela relacionados, julgue o item a seguir.
A presença de mutação no alelo do fator VIII permite concluir que havia outro hemofílico na cena do crime, com o genótipo XYH, já que a hemofilia é uma doença genética recessiva ligada ao cromossomo Y.
No que se refere a citoesqueleto, movimento celular e processos de obtenção de energia na célula, julgue o próximo item
Com a morte do indivíduo, os processos de geração de energia ficam comprometidos, a produção de ATP cessa e os estoques citoplasmáticos de ATP são consumidos, o que impede, por exemplo, a polimerização da actina e o deslizamento da miosina sobre o filamento de actina durante a contração muscular.
Internet: https://laminoteca.wixsite.com.
A imagem anterior foi obtida a partir de amostras de sangue coletadas em uma cena de crime para fins de isolamento de DNA. Várias células foram observadas, mas uma delas (indicada pela seta) apresentava um aspecto morfológico diferenciado. Com base nessa imagem, julgue o item seguinte.
A célula indicada encontra-se em mitose na fase de prófase, que se caracteriza pelo desaparecimento da carioteca e espiralização do material genético.
O uso de campos elétricos gerados no corpo humano tem sido objeto de estudo no que diz respeito ao desenvolvimento de redes de comunicação de dados. Aplicações projetadas para esse sistema de comunicação são ilimitadas e entre elas destaca-se o fato de indivíduos poderem, entre outras ações: trocar informações entre os seus aparelhos celulares A e B, usando apenas um aperto de mãos, como esboçado na figura I; transferir dados entre aparelhos eletrônicos A e B usando as duas mãos, como na figura II; imprimir dados apenas tocando na impressora; armas que funcionarão apenas com o seu proprietário; e eliminar a invasão por hackers. Nesse sistema de comunicação, o corpo humano funciona como um fio condutor ôhmico conectando equipamentos. Estudos recentes mostram que esse sistema de rede de comunicação entre aparelhos, denominado RedTacton (HAN), é mais eficiente e seguro que os sistemas tradicionais tais como wi-fi, LAN, WAN, infravermelho, bluetooth.
Considerando essas informações e que correntes elétricas iguais ou superiores a 100 mA causam fibrilação ventricular letal em humanos, que a resistência elétrica média da superfície externa de corpo humano molhado é de 300 Ω e do corpo seco é de 100 kΩ, julgue o item a seguir.
No RedTacton, para a segurança do indivíduo, a voltagem entre os aparelhos de comunicação A e B não pode exceder a 30 V.
O uso de campos elétricos gerados no corpo humano tem sido objeto de estudo no que diz respeito ao desenvolvimento de redes de comunicação de dados. Aplicações projetadas para esse sistema de comunicação são ilimitadas e entre elas destaca-se o fato de indivíduos poderem, entre outras ações: trocar informações entre os seus aparelhos celulares A e B, usando apenas um aperto de mãos, como esboçado na figura I; transferir dados entre aparelhos eletrônicos A e B usando as duas mãos, como na figura II; imprimir dados apenas tocando na impressora; armas que funcionarão apenas com o seu proprietário; e eliminar a invasão por hackers. Nesse sistema de comunicação, o corpo humano funciona como um fio condutor ôhmico conectando equipamentos. Estudos recentes mostram que esse sistema de rede de comunicação entre aparelhos, denominado RedTacton (HAN), é mais eficiente e seguro que os sistemas tradicionais tais como wi-fi, LAN, WAN, infravermelho, bluetooth.
Considerando essas informações e que correntes elétricas iguais ou superiores a 100 mA causam fibrilação ventricular letal em humanos, que a resistência elétrica média da superfície externa de corpo humano molhado é de 300 Ω e do corpo seco é de 100 kΩ, julgue o item a seguir.
Na aplicação esboçada na figura II, elétrons fluirão pela superfície do corpo do indivíduo no sentido do maior para o menor potencial elétrico.